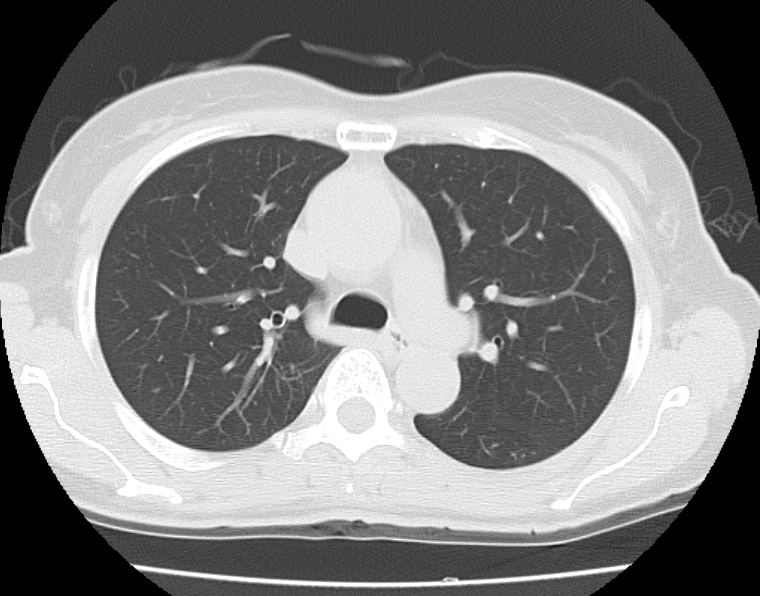

こんにちは!南⼤阪病院 放射線科です!放射線科コラム初めての発⾏です。
今回はCT検査についてわかりやすくご紹介します!
CT検査とは
CTとは、Computed Tomography(コンピュータ断層撮影)の略称です。レントゲンと同じX線を使⽤した検査となります。
CTはドーナツ状の筒があり、体がこの筒を通る際にX線を体に照射し、撮影を行います。 この時、体の中の成分によってX線の通り抜ける量が変わります。密度の⾼い⾻などはX線が通り抜けにくく、画像では⽩く映ります。反対に、空気が多く密度が低い肺などはX線が通り抜けやすく、画像では黒く映ります。このX線の通り抜ける量の差を画像化することで、普段よくみられるCT画像となります。

CT画像の活用
撮影された画像データを⽤いて、様々な⾓度から体を観察できます。よく使われるのは、体を横からみた⽮状断(サジタール画像)、体を正⾯からみた冠状断(コロナール画像)です。また3D画像も作成可能です。⼿術や検査結果の説明に使⽤されています。


当院の装置について
マルチスライスCT(多列検出器CT)です。この多列検出器とは、X線を受け取る部分(検出器)が複数並んでいる装置のことです。⼀度に撮影できる範囲が増え、検査時間が短くなります。撮影部位によっては、約5秒での撮影が可能となります。

また、画像のノイズや放射線被ばくを低減するAiCEという機能や⾦属による画像の影響を軽減するSEMARという機能が備わっております。そのため、⼿術などで体内に⾦属を留置していてもCT画像への影響が少なくなりました。

股関節に金属が留置されています。ORIGINAL画像では、金属の周りが黒く抜けてしまっており、診断がしにくいです。SEMAR画像では、黒く抜けている部分が改善されています。
造影検査
CTの検査には、静脈から造影剤を注⼊して撮影をする造影検査があります。造影剤を 使⽤することで、⾎管や臓器の⾎流の変化などを検査できます。また、⽩と黒の濃淡の差がより強調されることで、正常部位と腫瘍などを⾒分けることにも⽤いられます。

被ばくについて
CT検査は、放射線を使用する検査であり、被ばくを伴います。そのため、患者さんの病態にあわせて必要と判断された場合のみ施⾏します。さらに被ばくに関して、出来る限り少ない放射線量で検査をするように⽇々努めております。ぜひ安⼼して、検査を受けていただきたいと思います。
最後に
今回は、CT検査について簡単にご紹介しました。
CT検査は緊急で⾏われることも多く、⽇中を通して常時稼働しています。そのため、検査を受けられる方にはお待ちいただくことがあり、また救急の患者さんの対応のため、順番が前後する場合もございます。
ご理解とご協⼒のほど、よろしくお願いいたします。
CT検査に関する造影検査や被ばくに関することなど、今後の【放射線科コラム】で詳しくご紹介していく予定です。 次回もぜひご覧ください。
ご不明な点やご不安なことがございましたら、どうぞお気軽に放射線技師や医療スタッフにお声がけください。